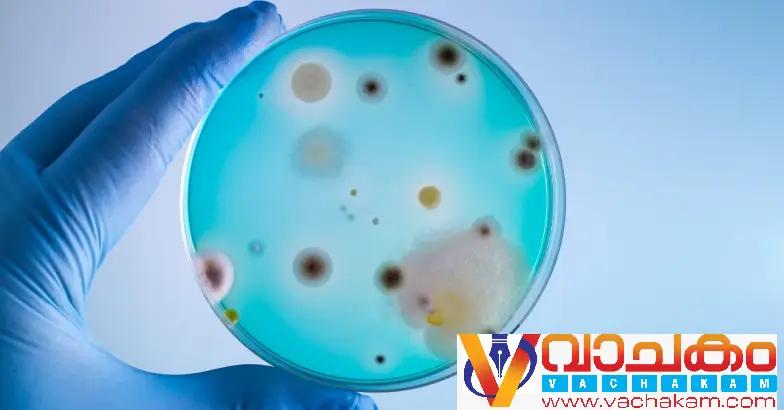

തിരുവനന്തപുരം: കേരളത്തിന്റെ സ്വന്തം സൂക്ഷ്മാണു ഏതെന്ന് അറിയാന് ഇനി ദിവസങ്ങള് മാത്രം. സംസ്ഥാന മൃഗം, പക്ഷി, വൃക്ഷം, ഫലം, പുഷ്പം എന്നിവയെപ്പോലെ സ്വന്തമായി സംസ്ഥാനത്തിന്റെ സൂക്ഷമാണുവിനെ (മൈക്രോബ്) പ്രഖ്യാപിക്കാനൊരുങ്ങുകയാണ് കേരളം. 23 ന് തിരുവനന്തപുരം കഴക്കൂട്ടം കിന്ഫ്രിയിലെ സെന്റര് ഫോര് എക്സലന്സ് ഇന് മൈക്രോബയോമില് സംഘടിപ്പിക്കുന്ന പരിപാടിയില്വച്ച് മുഖ്യമന്ത്രി പിണറായി വിജയന് സംസ്ഥാന സൂക്ഷ്മാണുവിനെ പ്രഖ്യാപിക്കും.
ഇതോടെ മനുഷ്യ ജീവിതത്തെയും പരിസ്ഥിതിയെയും ആഴത്തില് സ്വാധീനിക്കുന്ന സൂക്ഷ്മാണുക്കള്ക്ക് സംസ്ഥാനതല അംഗീകാരം നല്കുന്ന രാജ്യത്തെ ആദ്യ സംസ്ഥാനമായി കേരളം മാറും.
സാധാരണയായി രോഗകാരികളെന്ന ധാരണയില് മാത്രം പൊതുസമൂഹം നോക്കിക്കാണുന്ന സൂക്ഷമാണുക്കള് ദഹനം, രോഗപ്രതിരോധം, മണ്ണിന്റെ ആരോഗ്യ സംരക്ഷണം, മികച്ച വിളവ്, പരിസ്ഥിതി സന്തുലനം തുടങ്ങിയ മേഖലകളില് ഗുണകരമായ പങ്കുവഹിക്കുന്നുണ്ടെന്നാണ് പഠനങ്ങള് പറയുന്നത്. ദൈനംദിന ജീവിതത്തില് സൂക്ഷ്മാണുക്കള് നല്കുന്ന അനന്തമായ ഗുണഫലങ്ങളെക്കുറിച്ചുള്ള പൊതുചര്ച്ചയ്ക്ക് വേദിയൊരുക്കുക എന്ന ലക്ഷ്യത്തോടെ സെന്റര് ഓഫ് എക്സലന്സ് ഇന് മൈക്രോബയോമിന്റെ ഡയറക്ടറായ ഡോ. സാബു തോമസാണ് സംസ്ഥാന സൂക്ഷ്മാണു എന്ന ആശയം മുന്നോട്ടുവച്ചത്. ആരോഗ്യ-പരിസ്ഥിതി മേഖലകളില് സൂക്ഷ്മാണുക്കളുടെ പ്രാധാന്യം അംഗീകരിക്കുകയും അവയുടെ സംരക്ഷണം പ്രോത്സാഹിപ്പിക്കുകയും ചെയ്യുന്നതിന് ഈ നീക്കം സഹായകരമാകുമെന്നാണ് വിലയിരുത്തല്.
നിര്ദ്ദേശം അംഗീകരിച്ച സംസ്ഥാന സര്ക്കാര് കേരള സംസ്ഥാന ശാസ്ത്ര സാങ്കേതിക പരിസ്ഥിതി കൗണ്സിലിന്റെ എക്സിക്യൂട്ടീവ് വൈസ് പ്രസിഡന്റ് അധ്യക്ഷനായ വിദഗ്ധ സമിതി രൂപീകരിച്ചു. ക്ലിനീഷ്യന്മാര്, ശാസ്ത്രജ്ഞര്, പ്രൊഫസര്മാര്, സംസ്ഥാന ജൈവവൈവിധ്യ ബോര്ഡ് പ്രതിനിധികള് തുടങ്ങിയവര് ഉള്പ്പെട്ട ഈ സമിതിയാണ് സംസ്ഥാന സൂക്ഷ്മാണുവിനെ തിരഞ്ഞെടുത്തത്.
രോഗകാരിയല്ലാത്തതും, കേരളത്തില് നിന്ന് റിപ്പോര്ട്ട് ചെയ്തതും, വിവിധ മേഖലകളില് പ്രയോഗയോഗ്യവും സാമ്പത്തിക മൂല്യമുള്ളതും, GRAS (Generally Recognized As Safe) പദവി ലഭിച്ചതുമായ സൂക്ഷമാണുവിനെയാണ് തിരഞ്ഞെടുത്തിട്ടുള്ളത്. മനുഷ്യ, മൃഗ, ജല, സസ്യ, പരിസ്ഥിതി മേഖലകളിലെല്ലാം ഗുണകരമാകുന്ന ബാക്ടീരിയയാണ് ഇത്.
2013ല് ലാക്ടോബാസില്ലസ് ഡെല്ബ്രൂക്കീ സബ്സ്പ്. ബള്ഗാരിക്കസ് (Lactobacillus delbrueckii subsp. bulgaricsu) എന്ന ബാക്ടീരിയയെ ഇന്ത്യയുടെ ദേശീയ സൂക്ഷമാണുവായി പ്രഖ്യാപിച്ചിരുന്നു. പുളിപ്പിക്കല് പ്രക്രിയയിലൂടെ ദഹനസഹായവും പ്രതിരോധശക്തി വര്ധനയും നല്കുന്ന പ്രോബയോട്ടിക് ഗുണങ്ങളുള്ള ബാക്ടീരിയയാണ് ഇത്.
വാചകം ന്യൂസ് വാട്ട്സ് ആപ്പ് ഗ്രൂപ്പിൽ പങ്കാളിയാകുവാൻ
ഇവിടെ ക്ലിക്ക് ചെയ്യുക
.
വാട്സ്ആപ്പ്:ചാനലിൽ അംഗമാകാൻ ഇവിടെ ക്ലിക്ക് ചെയ്യുക .
ഫേസ്ബുക് പേജ് ലൈക്ക് ചെയ്യാൻ ഈ ലിങ്കിൽ (https://www.facebook.com/vachakam/) ക്ലിക്ക് ചെയ്യുക.
യൂട്യൂബ് ചാനൽ:വാചകം ന്യൂസ്
